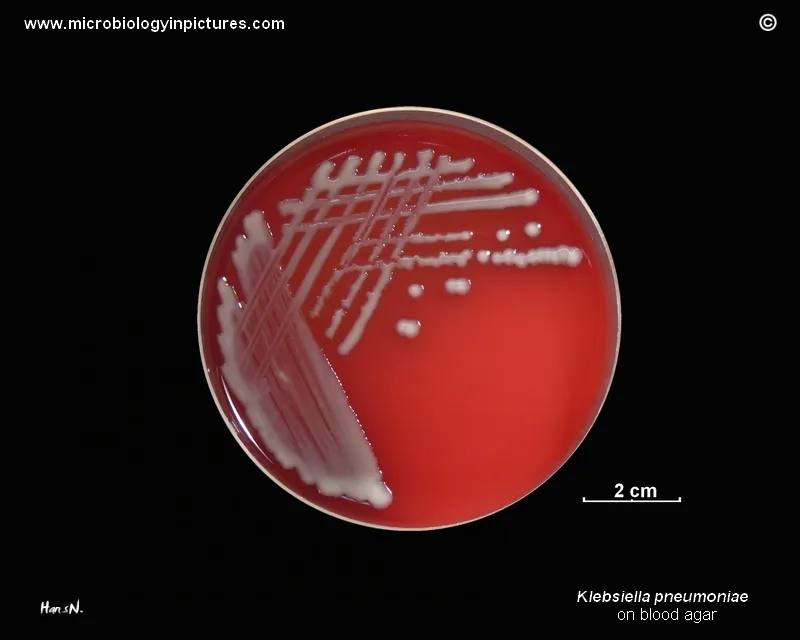
Klebsiella pneumoniae mucoid colonies on blood agar

Klebsiella ID - The Encapsulated Offender
- Microscopy & Culture: Gram-negative, enteric bacillus. Forms large, mucoid, glistening colonies on agar due to its prominent polysaccharide capsule.
- Biochemical Markers:
- Lactose fermenter (pink colonies on MacConkey agar).
- Urease positive.
- Indole negative (helps differentiate from E. coli).
- Key Virulence Factor: A thick, anti-phagocytic polysaccharide capsule is its hallmark. This results in a positive "string test."
⭐ The extensive capsule leads to the production of thick, mucoid, blood-tinged sputum, famously known as "currant jelly" sputum, in pneumonia patients.
Virulence Factors - Slimy & Dangerous
- Polysaccharide Capsule: The primary virulence factor; a thick, mucoid layer.
- Prevents phagocytosis and complement-mediated killing.
- Gives colonies their characteristic slimy, mucoid appearance.
- Hypervirulent strains (hvKp) exhibit a hypermucoviscous phenotype.
- LPS (Endotoxin): A core component of the Gram-negative outer membrane.
- Triggers a potent inflammatory cascade, leading to fever and septic shock.
- Adhesins (Fimbriae): Mediate binding to host epithelial cells, essential for colonization, particularly in the urinary and respiratory tracts.
- Siderophores: High-affinity iron-chelating compounds (e.g., enterobactin) that sequester host iron, which is vital for bacterial growth.
⭐ The extensive capsule is responsible for the thick, mucoid, blood-tinged sputum classically described as "currant jelly" sputum in severe pneumonia.

Clinical Disease - The 3 A's
-
Aspiration Pneumonia:
- Classic in debilitated hosts, especially Alcoholics and Diabetics.
- Produces thick, mucoid, blood-tinged sputum ("currant jelly").
- CXR: Lobar consolidation, often in posterior upper lobes, with potential for cavitary lesions or abscess. The "bulging fissure" sign is a classic finding.

-
Abscesses:
- High propensity for abscess formation due to its thick capsule.
- Most notably causes pyogenic liver abscess, often with metastatic spread.
- Also a cause of lung, brain, and splenic abscesses.
-
UTIs & Bacteremia:
- Major cause of nosocomial UTIs, particularly in catheterized patients.
- Frequently leads to bacteremia, sepsis, and septic shock, especially in hospitalized patients.
⭐ Klebsiella granulomatis (formerly Calymmatobacterium granulomatis) causes Granuloma Inguinale (Donovanosis), an STI with painless, "beefy-red" genital ulcers. Diagnosis relies on identifying Donovan bodies-bacteria within macrophages-on tissue smear.
High‑Yield Points - ⚡ Biggest Takeaways
- Klebsiella is a gram-negative, lactose-fermenting rod with a prominent polysaccharide capsule.
- The thick mucoid capsule is a key virulence factor, leading to a mucoid look on agar.
- Classically causes lobar pneumonia in alcoholics and diabetics, often with abscess formation.
- Produces thick, bloody sputum famously described as "currant jelly" sputum.
- A major cause of nosocomial UTIs, especially in catheterized patients.
- Remember the 3 A's: Aspiration pneumonia, Abscesses, and Alcoholics.
- Carbapenem-resistant Klebsiella pneumoniae (KPC) is a significant public health threat.
Unlock the full lesson and continue reading
Signup to continue reading this lesson and unlimited access questions, flashcards, AI notes, and more